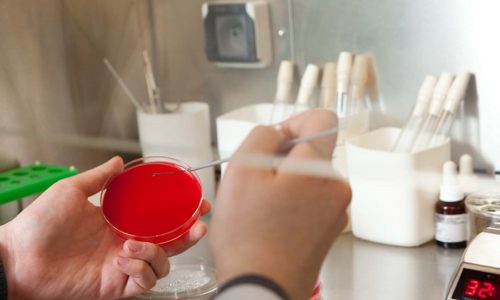

Які аналізи здати при циститі у жінок Нирки
Аналіз сечі по Нечипоренко
Цистит, як і більшість інших захворювань, зустрічається у двох формах: гостра і хронічна. У кожної з них є свої ознаки.
- печіння і різь в уретрі;
- прискорені позиви до сечовипускання;
- разова порція сечі зменшується до 15 мл;
- хворобливі і утруднені сечовипускання;
- каламутна сеча;
- болючість в мошонці, паху, статевому члені, а також в області лобка;
- сеча має запах гнилі і може містити домішки слизу або крові.
Дуже часто поява циститу у чоловіків супроводжується хронічним простатитом.
- печіння та свербіж статевих губ;
- постійні сечовипускання, під час яких з’являється різкий біль;
- мутний відтінок сечі з появою в ній крові і слизу.
Гострий цистит проходить через одну-два тижні успішного лікування. Якщо після закінчення цього часу симптоми не зникли, то захворювання переходить в хронічну стадію. Її можна розпізнати за наявністю все тих же симптомів, але вже в меншій мірі їх вираженості – дуже часто спостерігаються болі внизу живота і нетривалі позиви до сечовипускання. При цьому в крові та сечі спостерігається підвищення рівня лейкоцитів та еритроцитів.
Для попередження розвитку захворювання потрібно дотримуватися дуже прості, але, в теж час, важливі правила:
- не переохолоджуватися;
- не допускати, щоб сечовий міхур перебував у переповненому стані;
- не забувати про особисту гігієну;
- не носити сильно стягуюче нижня білизна;
- як можна більше пити свіжі соки і вживати в їжу фрукти та овочі;
- при туалеті статевих органів застосовувати засоби, що мають нейтральний кислотно-лужний баланс.
Цистит являє собою досить таки підступне захворювання, яке вимагає адекватної та своєчасної діагностики. До основним ознаками запального процесу сечового міхура відносять:
- характерні скарги жінок на хворобливе сечовипускання, печіння;
- болі внизу живота у жінок;
- домішки чужорідних утворень в сечі (кров’янисті);
- занепад сил та погане самопочуття загального плану (іноді з підвищенням температури тіла).
При виявленні типових чинників, жінці потрібно звернутися в медичний заклад і пройти адекватне лікування. Лікування потрібно пройти в обов’язковому порядку, щоб надалі не виникло патологій щодо вагітності і виношування. Аналізи при циститі є типовими дослідженнями:
- Місцевий огляд гінеколога потрібно пройти для здачі мазка для оцінювання флори піхви і на фактор прихованих інфекційних захворювань.
- УЗД фахівець призначає при необхідності і підозрі ускладнень захворювання сечового міхура.
- Здати кров, аналіз якої покаже патологію (факт проистекания запального процесу).
- Загальний аналіз урини.
Загальний аналіз урини являє собою скринінгове дослідження, проведене в рамках моніторингу загального стану діяльності внутрішніх органів, зокрема нирок і сечового міхура та сечовидільної системи.
Білок в сечі при циститі говорить про перехід запалення у вигляді інфекції на нирки, лікування яких тривалий. Ниркова недостатність (або патологія) виявляється при виявленні показника еритроцитів (більше 3-х). Даний фактор стосується і сечового міхура.
- Аналіз сечі по Нечипоренко.
У сечі середовище для досліджень більш інформативна. Показники в сечі виявляють оцінку осаду біоматеріалу з еритроцитами і лейкоцитами.
- Бактеріологічний посів на виявлення патогенної мікрофлори в сечі.

Даний аналіз виявить не тільки патогенні організми, але і розповість, вид яких антибіотиків підійде для конкретного лікування. Так в процесі лабораторних досліджень у сечі вишукуються мікроорганізми, на яких протягом декількох днів випробовуються препарати.
- Аналіз на гормони лікар може призначити за умови, що огляд показав деякі підозри порушення діяльності щитовидної залози, яка дає гормональний збій всієї ендокринної системи.
- ПЛР діагностика здатна вловити весь спектр мікро збудників: герпес, хламідії, трихомонади, уреплазмы.
У клінічному аналізі крові при легкому перебігу циститу зазвичай не виявляють патологічних змін. У тяжких клінічних випадках при гнійному процесі виявляють ознаки запалення – лейкоцитоз (більше 7-9×10*9), нейтрофільоз (більше 6%), зсув лейкоцитарної формули вліво, підвищення ШОЕ (більше 15 мм/год).
Реакція з боку периферичної крові буде більш яскраво виражена у дитини, чим у дорослих пацієнтів.
Для виявлення патологічних змін в сечі призначають загальний аналіз – рутинний метод лабораторної діагностики захворювань сечовидільної системи. Обстеження дозволяє визначити зміни у властивостях сечі:
- Колір;
- Прозорість;
- Запах;
- Питома щільність;
- Вміст кетонових тіл, білка, жовчних кислот;
- Лейкоцити;
- Еритроцити;
- Циліндри;
- Епітеліальні клітини;
- Солі;
- Бактерії, грибки.
Діагностика циститу за допомогою загального аналізу сечі виявляє збільшення кількості лейкоцитів (понад 5 у полі зору), еритроцитів (більше 3 в полі зору), епітелію (понад 8 в полі зору), поява білка і зниження прозорості за рахунок домішки слизу або гною. Обстеження дозволяє виявити присутність патогенних бактерій і грибів.
Аналізи при визначенні циститу у жінок вимагають правильного збору сечі.
- Гігієна зовнішніх статевих органів – область промежини обмивають теплим мильним розчином, потім осушують чистим рушником;
- Сечу збирають у стерильний контейнер вранці після сну;
- При зборі біоматеріалу необхідно розсунути статеві губи;
- Не слід проходити обстеження в період менструації;
- Сечу доставляють у лабораторію протягом 1-2 годин;
Від дотримання правил збору біоматеріалу залежить результативність обстеження.
При виникненні перших симптомів циститу необхідно звернутися за консультацією фахівця для проходження своєчасної діагностики і призначення терапії. Визначити необхідний перелік аналізів може терапевт, гінеколог, уролог, нефролог.
Зазвичай пацієнти звертаються за допомогою до терапевта, який призначає первинну діагностику і при необхідності направляє хворих на консультацію до лікарів вузької спеціалізації.
Обстеженням дитини займається дільничний педіатр і дитячий нефролог. Раннє звернення за медичною допомогою попереджає перехід гострої форми циститу у хронічний перебіг захворювання.
Для постановки діагнозу досить характерної симптоматики та результатів загальних аналізів сечі і крові. Але медична практика розрізняє хронічний і гострий цистит: етіологія — бактеріальний, паразитичний, радіаційний, алергічний, морфологія — геморагічний, виразковий, інтерстиціальний і гангренозний.
Ця класифікація — основа диференціальної діагностики. Необхідні аналізи уролог призначає:
- Загальний аналіз сечі. Виявляє патоген, що викликає інфекцію.
- Бактеріологічне дослідження сечі. Визначає чутливість мікрофлори пацієнта до певних антибіотиків.
- Дослідження по Нечипоренко. Оцінюють ступінь запального процесу сечовивідних шляхів.
- Аналіз за методом Аддиса-Каковского. Визначає кількість еритроцитів, циліндрів і лейкоцитів у сечі за добу.
- Загальний аналіз крові.
- УЗД сечового міхура.
- Цистоскопія. Виявляє патології сечового міхура.
Якщо симптоми циститу повторюються через 1-4 тижні після закінчення терапії, проводяться додаткові тести.

Загальний аналіз сечі виявляє патоген, що викликає інфекцію.

Загальний аналіз крові: норма і відхилення.

Дослідження по Нечипоренко оцінює ступінь запального процесу сечовивідних шляхів.

Цистоскопія виявляє патології сечового міхура.

Аналіз за методом Аддиса-Каковского визначає кількість еритроцитів, циліндрів і лейкоцитів у сечі за добу.

УЗД сечостатевої системи проводиться для виключення інших захворювань.
У жінок
Цистит через анатомічних особливостей у жінок викликається гінекологічними захворюваннями, бактеріями і грибковими інфекціями. Тому жінки додатково складають:
- бактеріологічний посів сечі на умовно-патогенну мікрофлору;
- аналіз мікрофлори піхви на дисбактеріоз;
- цистоскопію.

Для диференціальної діагностики циститу у жінок використовуються:
- ПЛР-діагностика — дослідження генетичного матеріалу: крові, слизу, виділень з статевих органів;
- УЗД сечостатевої системи для виключення інших захворювань.
Жінки додатково здають бактеріологічний посів сечі на умовно-патогенну мікрофлору.
У чоловіків
Крім загальних аналізів крові та сечі, діагностувати цистит у чоловіків допомагають інші дослідження:
- УЗД нирок;
- цистоскопія;
- мазок на ІПСШ (інфекції, що передаються статевим шляхом).
Чоловікам при необхідності рекомендують комплексне обстеження статевих органів, передміхурової залози, урофлоуметрію (визначення швидкості сечовипускання). Дослідження дозволять визначити зв’язок симптомів циститу з простатитом і фімозом.

Крім загальних аналізів крові та сечі чоловікові рекомендується здати мазок на ІПСШ (інфекції, що передаються статевим шляхом).
У дітей
Для визначення діагнозу у дітей загальний аналіз крові і сечі обов’язковий. Кров може показати незначну запальну реакцію. Аналіз сечі, навпаки, виявить приховану патологію зростанням кількості лейкоцитів, появою еритроцитів, гною, бактерій і т. п.
Дітям призначають та інші лабораторні дослідження сечового міхура. Доцільно проведення ультразвукового обстеження при повному наповненні сечового міхура. Іноді проводять аналіз середньої порції сечі при нормальному сечовипусканні.
Загальний аналіз крові вказує на запальний процес у сечовидільній системі. Діагностика базується на кількості лейкоцитів, функція яких — розпізнавання чужорідних патогенних мікроорганізмів.
Збільшення білих кров’яних клітин в крові — свідоцтво запалення, зараження вірусами, появи пухлин. Але кількість цих клітин зростає і при підвищеному фізичному навантаженні, алергії. Діагностувати цистит, грунтуючись тільки на даному факторі, що свідчить про патологію, складно.
Тоді проводять біохімічний аналіз крові та інші лабораторні дослідження.
Сеча здається при підозрі на цистит. В сечі в більшій кількості присутні лейкоцити та епітеліальні клітини, інколи — еритроцити. Її прозорість змінюють солі сечової кислоти та наявність білка.
Кислотність сечі при цій патології зменшується, а відносна щільність стає вище норми. Результати тесту допоможуть однозначно діагностувати цистит.
Причини
Більше всіх даному захворюванню схильні жінки. Причиною цього є дуже близьке розташування сечівника до піхви і заднього проходу, звідки і «добираються» різні бактерії в сечовий міхур.
- кишкова паличка;
- гриби Кандида;
- амеба протей;
- стрептококи (особливо фекальні);
- трихомонада;
- клебсієла;
- стафілококи.
Також варто врахувати, що існує велика кількість факторів, які провокують розвиток цих бактерії і відповідно інфекції сечостатевих шляхів:
- наявність якого-небудь перешкоди для виходу сечі, наприклад, камінь в сечовому міхурі;
- переохолодження організму;
- застосування засобів контрацепції, у вигляді внутрішньоматкової спіралі;
- аномальний розвиток сечостатевих шляхів, наприклад, при сильно занижений розташування отвору уретри. Ймовірність попадання бактерій в цьому випадку значно зростає;
- сексуальна активність анального типу збільшує ризик захворювання циститом в кілька разів;
- зміна гормонального фону (наприклад, при вагітності);
- зниження імунних властивостей організму. Наприклад, наявність у людини злоякісної пухлини, цукрового діабету, ВІЛ-інфекції або просто в міжсезонний період;
- постійне застосування уретрального катетера, який використовується для процесу відведення сечі у літніх людей або лежачих хворих. При цьому відбувається підвищення уразливості сечових шляхів, чим і користуються» бактеріальні інфекції;
- запальні захворювання кишечника, який має дуже близьке розташування з сечовим міхуром;
- носіння тісної білизни, яку тисне на сечовий міхур;
- простудні захворювання (тонзиліт, грип, ангіна тощо). Що циркулює по всьому організму кров може розносити бактерії до всіх органів, у тому числі і до сечового міхура.
Також існує так званий неінфекційний цистит, причини, появи якого полягають у подразненні сечового міхура хімічними речовинами, що виходять назовні разом з сечею. Найпоширеніший шлях їх потрапляння в організм – прийом лікарських препаратів.
Методи діагностики захворювання
Про те, які аналізи здають при циститі, пацієнтку інформують при первинному обстеженні, яке входить гінекологічний огляд і збір анамнезу хвороби. Хвороба відноситься до області урологічних захворювань, але її лікуванням займається гінеколог.
При циститі хворі скаржаться на прискорене і хворобливе сечовипускання, болі і різі в області статевих органів і надлобковій зоні. Гостра форма хвороби може супроводжуватися підвищенням температури тіла.
- клінічний (загальний) аналіз сечі;
- аналіз урини по Нечипоренко;
- мікроскопічне дослідження піхвової мікрофлори (мазок);
- загальний аналіз крові;
- посів сечі на спеціальну середу на флору для росту мікробів в термостаті (7-10 днів).
Для уточнення діагнозу можуть знадобитися:
- дані цистоскопії;
- проведення УЗД;
- ПЛР (полімеразна ланцюгова реакція).
За результатами цих досліджень цистит визначається навіть на ранніх стадіях. При наявності захворювання склад крові і сечі змінюється – в них виявляються елементи, що вказують на розвиток запального процесу в сечостатевій системі.
Лабораторний мінімум при циститі включає клінічний аналіз крові, загальний аналіз сечі, аналіз сечі по Нечипоренко. У тяжких клінічних випадках проводять ПЛР сечі.
З метою визначення виду патогенної мікрофлори та її чутливості до антибіотиків вдаються до культурального методу дослідження. Для встановлення причини запального процесу в сечовому міхурі у жінок беруть мазки з піхви на визначення мікрофлори та статевих інфекцій.
Діагностика при циститі культуральним методом призначається для виявлення причини запальної реакції з боку сечового міхура. Сечу сіють на поживні середовища. Через 7-10 днів отримують колонії бактерій або грибів, які дали зростання.
Для підтвердження діагнозу цистит проводять УЗД (ультразвукове дослідження) сечостатевих органів. За допомогою обстеження визначають форму, розміри, контури сечового міхура, присутність сторонніх тіл, каменів, новоутворень.
У важких діагностичних випадках призначають цистоскопію – ендоскопічний метод дослідження сечового міхура за допомогою цистоскопа. УЗД і цистоскопія доповнюють лабораторну діагностику і допомагають провести адекватну терапію.
В кабінеті у лікаря потрібно докладно описати свої відчуття і скарги, на основі чого буде зібраний анамнез. Потім лікар огляне жінку візуально і зробить пальпацію, після чого відправить її на наступні діагностичні процедури.
- Загальний аналіз сечі, що дозволяє діагностувати цистит по її зовнішньому вигляду, запаху, консистенції і так далі.
- Аналіз сечі по Нечипоренко, який потрібно здати для того, щоб визначити кількість білих і червоних кров’яних тілець в сечі, що буде свідчити про запалення в органах видільної системи.
- Бактеріальний посів, необхідний для достовірного визначення типу збудника. Без бакпосіву неможливо правильно підібрати антибіотик, що особливо важливо це при хронічному циститі, оскільки при такій формі захворювання хвороботворні бактерії вже могли виробити стійкість до певних препаратів, тому потрібно підбирати новий.
- Взяття піхвового мазка на предмет наявності дисбактеріозу або інших порушень мікрофлори.
- Ультразвукове дослідження органів видільної і статевої системи, яке зазвичай використовується в тих випадках, коли аналізи сечі не допомогли достовірно визначити наявність циститу або розмах запального процесу, а також при ускладненнях і необхідності ретельно оглянути сечовий міхур, нирки і сечовивідні шляхи.
- Цитоскопия, що призначається тільки в самих крайніх випадках через хворобливості процесу. Цей метод дозволяє добре оглянути сечовий міхур зсередини, а також виявити зароджуються пухлини, але його не можна використовувати при гострому циститі через ймовірності посилити запальний процес.
Цистоскопія — це процедура огляду слизової оболонки сечового міхура. На необхідність її проведення вказують:
- післяопераційні проблеми сечового тракту, наявність запалення;
- гематурія (надлишок лейкоцитів);
- уролітіаз (утворення каменів);
- різні вади уретри і сечового міхура.
Цистоскопію проводять у лікарняних умовах під загальною (або місцевої) анестезією протягом 5-10 хвилин. Використовується спеціальний прилад з оптичним трубкою — цистоскоп, який вводиться в сечовий міхур через сечівник. Процедура дозволяє ретельно вивчити стан органу і взяти фрагменти тканини (біопсія).
В складних випадках для діагностики застосовуються рентгеноскопія, комп’ютерна, магнітно-резонансна томографія, УЗД. Іноді проводять цистографію — радіологічне дослідження з використанням контрастної речовини. Дослідження не проводиться при гострій формі циститу.

Цистоскопію обов’язково необхідне проводити при уолитиазе (утворення каменів).
Лікування
Для позбавлення від циститу обов’язкової госпіталізації не потрібно. Дане захворювання відмінно лікується і вдома. Для цього застосовують як лікування народними засобами, так і прийом різних лікарських препаратів.
Перше, що необхідно зробити при появі ознак запалення сечового міхура – це відмовитися від вживання солоних, гострих і жирних страв, алкогольних і газованих напоїв, а також кава і всього подібного.
- пити якомога більше компотів, відварів і різних чаїв. Рідина вимиває бактерії, що осіли на стінках сечового міхура;
- намагатися вживати в їжу перемелені продукти;
- виключити цукор.
Непогані рекомендації в лікуванні циститу отримала і народна медицина. Як правило, для цього застосовують відвари різних трав, які мають протизапальну або сечогінною дією. Наприклад, для цього можна скористатися шипшиною. Залити 4 ст. л.
Основною метою лікування циститу є знищення патогенних мікробів, що викликали захворювання. Єдиний метод позбавлення від них – це прийом антибактеріальних препаратів (Офлоксацин, Ципрофлоксацин тощо).
Критеріями вибору лікарського засобу служать: вид збудника, швидкість виведення препарату з організму, його вплив на ЖКГ (особливо при призначенні дітям), а також швидкість розподілу по організму.
Великою популярністю користуються ті препарати, концентрація яких відбувається саме в сечовому міхурі, що суттєво зменшує навантаження на всі інші органи і скорочує час лікування.
У комплексне лікування циститу входить і прийом протизапальних, а при необхідності, і знеболюючих ліків. Наприклад, препарат Уропрофит, має протимікробну, спазмолітичну та протизапальну дію.
Аналіз за Нечипоренком
Діагностика циститу методом Нечипоренко дозволяє з високою точністю визначити кількість лейкоцитів, циліндрів, еритроцитів в 1мл сечі. Для аналізу беруть середню порцію сечі. Підвищення вмісту лейкоцитів понад 2000/мл, циліндрів понад 20/мл еритроцитів понад 1000/мл свідчить на користь циститу.
Приховані інфекції між тим продовжують розвиватися, набувають стійкості до прийнятих препаратів. З часом не виявлений запальний процес призводить до серйозних ускладнень. При хронічному циститі можуть бути позитивні аналізи в латентний період. На цьому етапі хвороба не проявляється симптоматикою.

З цієї та інших причин лабораторна діагностика циститу включає одночасне проведення кількох урологічних тестів. Комбінування різних способів дослідження позитивно впливає на точність постановки діагнозу.
На результат аналізу при циститі впливають зовнішні фактори: харчування, вживання алкоголю, прийом сечогінних засобів, препаратів групи НПЗЗ. Перед відвідуванням уролога важливо звести прийом медикаментів до мінімуму. Точна діагностика — необхідна умова для одужання пацієнта.
Якщо симптоми циститу спостерігаються при хороших аналізах, уролог порекомендує проведення цистоскопії. Слизова оболонка міхура обстежується візуально, виявляється запальний процес і патологічні зміни.
Кров на аналіз теж здають, але його результати не дуже інформативні у сфері захворювань сечостатевої сфери і можуть свідчити лише про існування в організмі вогнища запального процесу.
Тому спочатку пацієнтку відправлять мочитися в баночку.
При візуальному огляді і безпосередньому аналізі складу сечі звертають особливу увагу на:
- колір;
- консистенцію і прозорість;
- вміст нітритів;
- вміст білка;
- вміст глюкози;
- кислотність;
- вміст гемоглобіну
| У здорової | У хворого | |
|---|---|---|
| Колір | Солом’яно-жовтий | Коричневий, можливий рожевий або червоний колір через домішки крові |
| Консистенція і прозорість | Прозора, без будь-яких домішок | Каламутна, часто видно плаваючі пластівці або частинки слизу |
| Вміст нітритів | Не повинні міститися | Спостерігаються |
| Вміст білка | Не міститься, або ж спостерігається в дуже малих кількостях | При запальному процесі кількість білка значно збільшується |
| Вміст глюкози | Не спостерігається | Міститься в сечі |
| Кислотність | Слабокисла | Кислотність значно нижче норми |
| Вміст гемоглобіну | Не утримується | Міститься і свідчить про гематурії |
Всі ці ознаки свідчать про наявність в організмі вогнища запального процесу, який необхідно терміново лікувати, поки цистит не перейшов в хронічну стадію.
Що стосується еритроцитів і лейкоцитів, при сильному запальному процесі їх кількість значно збільшується.
- Колір сечі вказує на кровотечу, присутність білірубіну, фенольних сполук (ознака отруєння), меланіну.
- Прозорість означає відсутність або присутність червоних кров’яних тілець, лейкоцитів, бактерій і грибів, що вказують на цистит.
- Питома вага. Перевищення норми (1018-1030 г/л) означає високий вміст білка в сечі, гною, глюкози або метаболітів ліків, а зниження — гостру або хронічну ниркову недостатність.
- Кислотність. Середнє значення pH — 6. Більш висока означає підвищений рівень калію, хронічну ниркову недостатність. Низьке — зневоднення або лихоманку.
- Уробіліноген. Знак « » є нормою, « » означає жовтяницю і відсутність цієї речовини — холестаз.

Небажані речовини в сечі:
- білок — його наявність вимагає додаткового обстеження;
- глюкоза вказує на діабет;
- білірубін пов’язаний із захворюваннями печінки.
Підготовка до УЗД сечового міхура
Нефролог відповідає на питання: види аналізів сечі
Розшифровка аналізу крові
Аналіз сечі розшифровуємо самі
Причини циститу у чоловіків
Цистит у жінок
Якщо загальне дослідження показує хороші аналізи при циститі без відхилень від норми, для уточнення діагнозу використовується аналіз за Нечипоренком — збір середньої порції (5-10 мл) ранкової сечі. У нормі В 1 мл сечі міститься не більше 2000 лейкоцитів, 1000 еритроцитів і 20 циліндрів.
Зниження кількості патогенної мікрофлори і лейкоцитів є показником ефективної терапії хвороби.
Бактеріальний посів
Такий аналіз необхідний для визначення типу збудника запалення в сечовому міхурі. В першу чергу в лабораторії обчислюють ДЕЩО колониеобразующую одиницю, яка може свідчити про те, що саме ця бактерія або вірус викликали запалення, або ж потрапили в сечу абсолютно випадково. Можливі наступні показники:
- менше 1000 одиниць на 1 мл – бактерії потрапили випадково і ніякого відношення до запалення не мають;
- більше 100000 – винуватець торжества знайдений і треба терміново шукати антибіотик, який його знищить;
- від 1000 до 10000 – можливі обидва варіанти і потрібно провести більш ретельне дослідження.
Після цього обов’язково потрібно зробити сам посів і перевірити на мікроорганізмах, ефективні проти них певні засоби. Бакпосів є найбільш потрібним аналізом при терапії циститу, оскільки хвороботворні бактерії і віруси мають властивість мутувати, після чого деякі антибіотики та протимікробні засоби стають неефективними і потрібно підбирати інший засіб.
Таким чином, відповіддю на питання, які аналізи потрібно в першу чергу здати при підозрі на цистит, є аналіз сечі. Це найбільш ефективний спосіб не тільки діагностувати захворювання, але і підібрати правильне ліки, яке допоможе швидко впоратися з неприємним недугою.
Що з себе представляють процедури?
Що потрібно від пацієнтки перед проходженням лабораторних досліджень? Напередодні не можна приймати лікарські препарати, щільно вечеряти, пити напої з сечогінним ефектом. Перед тим, як здавати аналіз сечі, необхідно придбати в аптеці спеціальний контейнер або підготувати чисту скляну ємність.
Основні види дослідження проводяться натщесерце. Перед відвідинами лікарні ретельно здійснюються заходи з особистої гігієни. Тільки при дотриманні цих умов показники аналізів при циститі будуть точними і достовірними.
- Аналіз крові при циститі – виражених змін не показує, але в рідині можуть бути виявлені антитіла, що вказують на присутність в організмі хвороботворних мікроорганізмів і вірусів.
- Аналіз сечі – обов’язкове включення в комплекс діагностичних процедур пояснюється тим, що за складом елементів в сечі (лейкоцити, еритроцити, білок, глюкоза та ін), а також наявності патогенної мікрофлори можна судити про дійсну причину хвороби.
- Дослідження урини по Нечипоренко – при проведенні процедури знадобиться середня порція сечі, в якій підраховується кількість елементів на 1 мл рідини. Перевищення рівня складових говорить про те, що в організмі розвивається інфекція або запальний процес.
- Дослідження мікрофлори внутрішніх статевих органів – береться зразок секрету в піхву, який потім досліджується під мікроскопом.
- Бактеріальний посів сечі – частина матеріалу залишається на предметному склі, фіксується покривним склом і ретельно розглядається під мікроскопом.
- Ультразвукове дослідження (УЗД) – призначається, як додатковий вид обстеження, якщо консервативне лікування не дає позитивної динаміки, і стан пацієнтки продовжує погіршуватися.
- Цистоскопія – цей вид інструментального дослідження дозволяє вивести зображення внутрішньої поверхні органів сечостатевої системи на монітор. Проводиться за допомогою спеціального пристрою, забезпеченого мініатюрною відеокамерою – цистоскопа. Процедура досить болюча, тому в ряді випадків потрібна анестезія.
- ПЛР (полімеразна ланцюгова реакція) – дослідження, що дозволяє шляхом багаторазового збільшення фрагментів ДНК виявити збудників інфекційних та венеричних захворювань.

Чи є якісь аналізи при циститі, які не використовуються при діагностиці? Деякі з означених вище процедур (наприклад, цистоскопія) не можуть проводитися в період гострого нападу хвороби і призначаються після того, як вдалося стабілізувати стан хворої і зупинити запалення.
Під час реабілітації жінкам потрібно уникати протягів (щоб не допустити переохолодження), правильно харчуватися, не вживати алкоголю і не курити. Організм сам намагається боротися з хворобою, запускаючи процеси самовідновлення. І якщо йому в цьому заважати, одужання може затягнутися на невизначений термін.
Швидкі аналізи: експрес-тест
Процес постановки діагнозу може затягуватися на декілька днів, які так болісно для жінок, які страждають на цистит. Тривалість діагностики обумовлена лабораторними дослідженнями, наприклад, мікрофлора вирощується кілька днів, і так далі, а лікування затягувати не можна.
Поліклініки приватного характеру організації на ряду з багатьма дослідницькими програмами, роблять експрес-тести. Швидкий тест-аналіз може фактично відразу поставити діагноз жінці протягом 1 дня.
Три типи експрес-тестування:
- 1-й тип тесту виявляє кількісний показник білка, еритроцитів і лейкоцитів у сечі;
- 2-й тест (з індикатором) покаже нітрити в сечі, які з’являються в біоматериалі допомогою проникнення патогенних мікроорганізмів;
- 3-й тест показує в сечі естеразу, що проявляється з гноєм.
Як правильно здавати аналізи
У дітей
Дослідження сечі і крові при циститі — база для комплексної діагностики. На достовірність результатів впливають помилки при заборі досліджуваного матеріалу і порушення санітарних норм проведення аналізу.
Але більше всього спотворює результат недотримання правил особистої гігієни самим пацієнтом. Важливі не тільки санітарні норми. На результати будь-яких аналізів впливають:
- прийом гострої, кислої, важкої їжі перед здачею аналізу;
- вживання забарвлюють сечу овочів і фруктів;
- менструальний цикл;
- куріння і вживання алкоголю незадовго до здачі матеріалів дослідження;
- прийом лікарських препаратів (сечогінних, проносних, залізовмісних) та ін.
Підсумки окремих видів дослідження крові спотворюються і після рентгенографії, УЗД, масажу і фізіотерапії.
Через 3-4 години після останнього прийому їжі допускається здача проб для проведення загального аналізу крові і ПЛР-діагностики, визначення групи та резус-фактору крові, антитіл до збудників інфекцій. Строго натщесерце проводять біохімічні, гормональні, імунологічні дослідження.

У день тестування утримуються від прийому прописаного ранкового ліки. Фізичні вправи небажані — вони теж впливають на результати тесту, оскільки порушують вуглеводну економіку, збільшують число нейтрофілів (різновид лейкоцитів), змінюють рівень гормонів. Перед здачею аналізу крові краще посидіти спокійно протягом півгодини.

На достовірність результатів аналізів впливають помилки при заборі, порушення санітарних норм проведення аналізу; прийом гострої, кислої, важкої їжі перед здачею аналізу; куріння і вживання алкоголю і інші фактори.
Збір сечових виділень проводять вранці. Перед здачею не вживають овочі, сік яких забарвлює сечу, не приймають проносні і сечогінні препарати. Жінки під час менструації здають сечу тільки в екстрених випадках.
Здається ранкова сеча, що скупчилася за ніч в сечовому міхурі. Перша струмінь спускається в туалет, а наступними наповнюють стерильний контейнер. Оптимальна кількість здаваної сечі — 50-100 мл.
Перед процедурою ретельно миють геніталії, застосовуючи туалетне мило. Використання антибактеріальних та антисептичних засобів зроблять дані аналізу недостовірними, оскільки штучно зменшиться кількість бактерій.
Здавати сечу в лабораторію треба своєчасно. Якщо сеча довго знаходиться в приміщенні, створюються сприятливі умови для розмноження патогенних мікроорганізмів.





